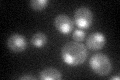
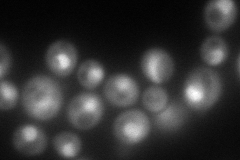
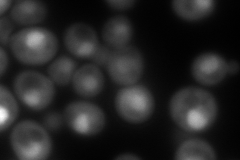
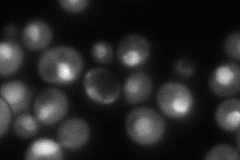
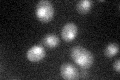

View description
Protein with ubiquitin-like N terminus, subunit of Nuclear Excision Repair Factor 2 (NEF2) with Rad4p that recognizes and binds damaged DNA; enhances protein deglycosylation activity of Png1p; homolog of human HR23A and HR23B
Localization:
Intensity:
Fold change:
Significance:
-
C’ GFP library in SD
nucleus39.5 -
N' NOP1pr-GFP in SD
cytosol,nucleolus170.941 -
N' TEF2pr-mCherry in SD
nucleus258.236 -
N' NATIVEpr-GFP in SD
nucleus129.127 -
N' TEF2pr-VC and Cyto-VN in SD

#N/A0 -
C’ GFP library in SD+DTT

nucleus33.560.84No -
C’ GFP library in SD+H2O2

nucleus30.940.78No -
C’ GFP library in Starvation Media
nucleus41.291.04No -
C’ GFP library on the background of Pup2-DaMP

nucleus -
C’ GFP library on the background of CCT mutant

nucleus42.02161.06353No
